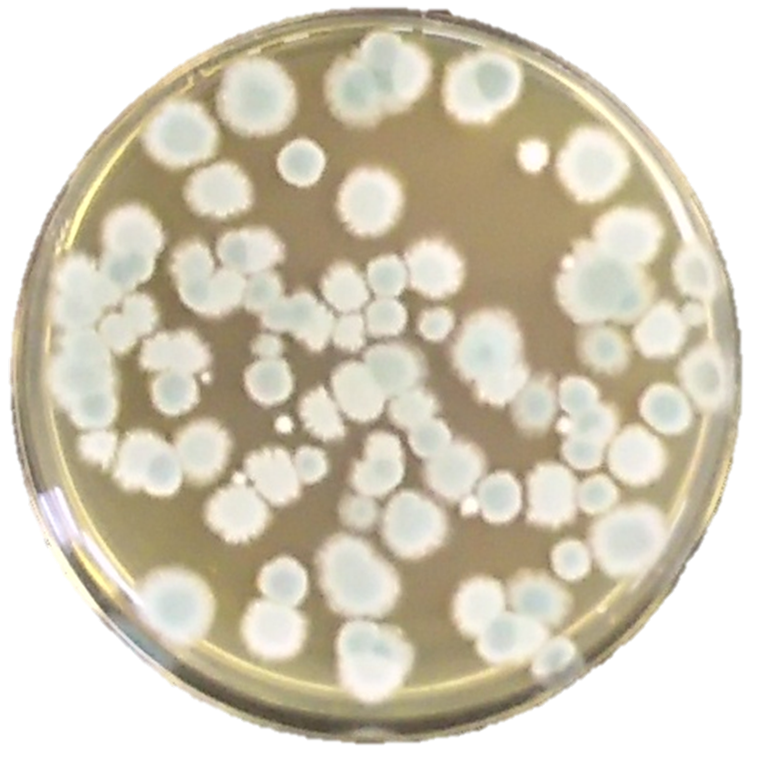
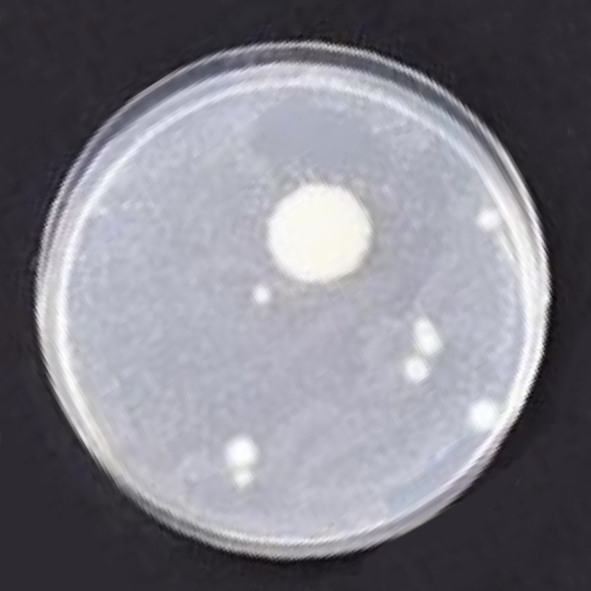

前回のコラムでは、冷蔵ショーケースの中にある「ハニカム」という部品が、どのような役割を果たしているのかをご紹介しました。
では実際に、そのハニカムは どの程度汚れているのでしょうか。
見えない場所で、少しずつ進行する変化
ハニカムは、売場から見えない位置に設置されています。空気の通り道である以上、そこには ホコリや油分、水分 などが、少しずつ付着していきます。これは、特別な環境でなくても起こり得る、ごく自然な現象です。

第三者機関による分析で確認された事実
こうした状態を客観的に確認するため、弊社では調査の一環として、大阪産業技術研究所に分析を依頼しました。その結果、汚れが付着したハニカムから、複数種のカビおよびバクテリアが検出されました。
※本調査は、特定の店舗や環境を断定するものではなく、ハニカムという部材の状態を確認する目的で実施したものです。

本画像は、大阪産業技術研究所における分析時に取得された顕微鏡画像です。
一見すると、白い円形の部分がカビやバクテリアそのもののように見えるかもしれませんが、白い円自体が単体のカビやバクテリアを示しているわけではありません。実際には、培地の背景色が変化している部分一帯に、カビやバクテリアが広く存在していることが確認されています。その中でも、特に微生物が高密度に集積し、増殖が飽和した領域が白く見えている状態です。
つまり、白い円は、カビやバクテリアが少ないことを示すものではなく、むしろ、その周囲を含めた広い範囲にわたって、相当数の微生物が存在している結果として現れた状態であると解釈されます。
数値で確認された「目に見えない汚れ」


あわせて、ルミテスター(ATP測定) を用いた検査も実施しました。ルミテスターは、目視では判断できない 有機物の存在量を数値として把握するための測定機器です。
測定の結果、ハニカム表面からは、有機物の存在が数値として確認されています。

食品衛生分野におけるRLUの運用基準では、医療機関や食品工場における手指の測定値は2,000以下とされるケースが一般的です。
こうした基準と照らし合わせると、今回確認された数値は、目に見えない汚れの存在を示すものとして、無視できない水準であることが分かります。
これらの数値は、「汚れている/汚れていない」と単純に判断するためのものではなく、目に見えない状態を客観的に把握するための一つの指標として取得したものです。
ここまで見てきたように、ハニカムの状態は、目視だけでは把握しにくい一方で、分析や測定によって確認できる側面があることが分かってきました。
それではなぜ、こうした状態がこれまで大きな問題として扱われてこなかったのでしょうか。
次回のコラムでは、「なぜ、これまで問題として認識されにくかったのか」 をテーマに、運用や認識の観点から整理していきます。

